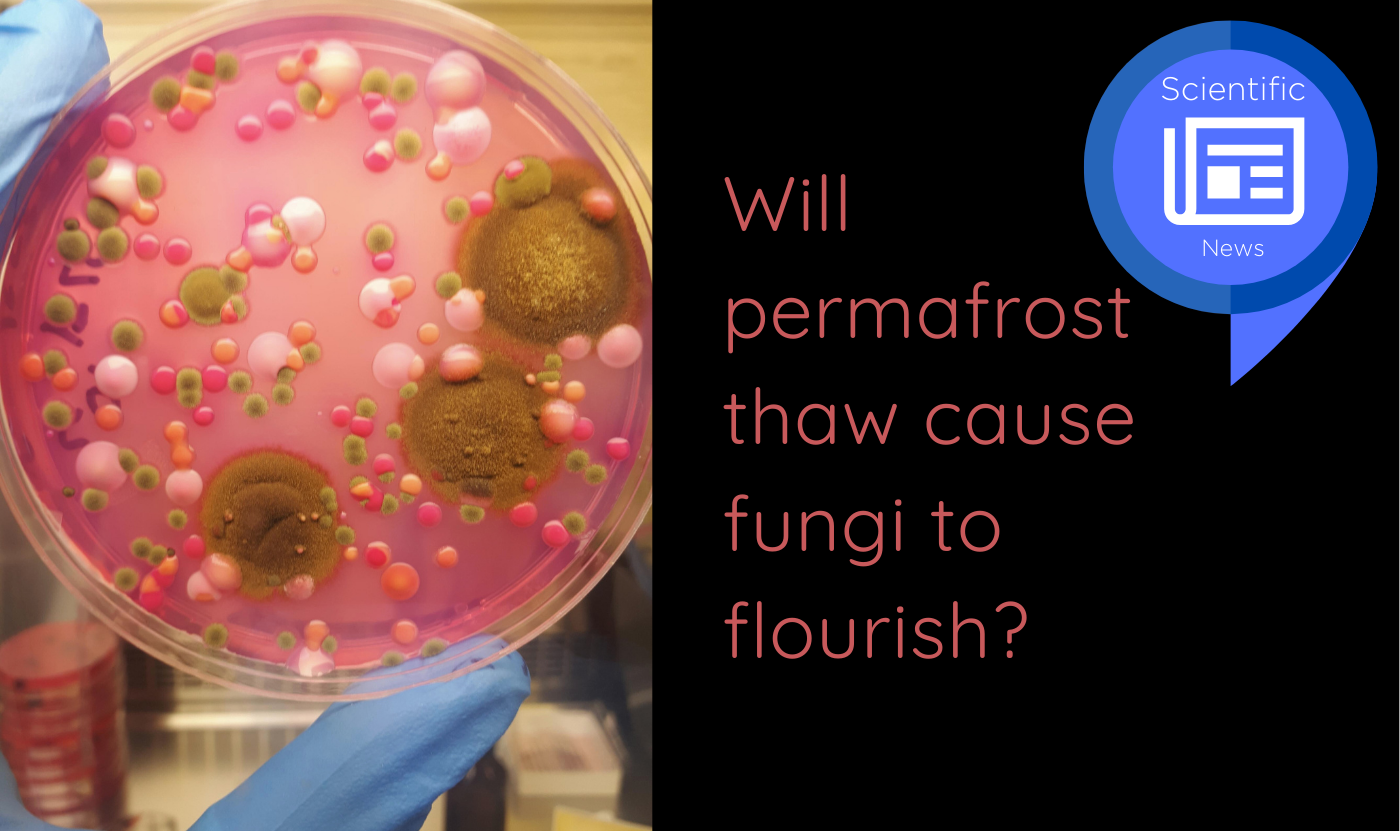
cover-scientific-news

On May 22, Quebec City hosted the provincial final of the science communication competition My Northern Project. Before an attentive panel of judges, 17 up-and-coming scientists brilliantly summarized their research in just 5 minutes. Congratulations to the four winners selected to represent Quebec on the international stage during the grand final!
News
PAP-27 will investigate the physical, biogeochemical, ecological, and societal connectivity between the Beaufort Sea, the Canadian Arctic Archipelago, and adjacent coastal systems through coordinated international research platforms and Indigenous partnerships.
Researchers from Quebec and Canada are eligible to apply.
From April 15 to May 29, Alexandra Bélanger is participating in the "Permafrost in Arctic Societies" field school in Sisimiut, Greenland. The Master’s student in Earth Sciences at Université Laval shares her experience here.
Check out our newsletter to catch up on our latest news. This newsletter was published on May 12, 2026. Don't forget to subscribe if you would like to receive it directly in your inbox.
These finalists, selected from our member universities, are vying for one of the four spots available for the international final in Iceland. Take a moment to discover the identity and projects of these up-and-coming researchers who are making northern research shine, and register for INQ Student Day! Open to all!
The virtual exhibition Inuit Worlds, from past to present highlights the richness of Canada’s Inuit culture, both past and present. This new trilingual educational tool, available in French, English, and Inuktitut, is intended for young Inuit, scientists working in the Arctic, and the general public interested in learning about Inuit history, heritage, and culture.
During her eight-year tenure at the Greenland Institute of Natural Resources in Nuuk, Professor Caroline Bouchard studied the population dynamics of Arctic cod. As noted in her study published in February 2026 in Arctic Science, the evidence points to one conclusion: the waters off southern Greenland are no longer suitable for the fish, and it is migrating northward.
Two new student positions are open at UQTR. Please consult the detailed descriptions and send your application directly to the project managers as specified in each offer.
Tuberculosis remains a persistent public health challenge in Nunavik. In 2025, the region crossed an alarming threshold, recording a record number of active cases. A study published in the Canadian Medical Association Journal examines this concerning situation.
On March 4, Jean-Éric Tremblay, Scientific Director of Institut nordique du Québec (INQ), played a key role at the 13th annual World Ocean Summit held in Montreal. This world-renowned event, organized by Economist Impact, brings together policy makers, investors, scientists, and Indigenous leaders. The goal is to move from major international agreements to concrete actions to protect and sustainably exploit our oceans.
In Nunavik, the thawing of permafrost is destabilizing buildings, leading to potential structural damage and water infiltration into the building envelope. This raises the question of how to detect water damage in walls before it is too late. Cindy Dumais is a doctoral student in Professor Caroline Duchaine's lab at the Institut Universitaire de Cardiologie et de Pneumologie de Québec at Université Laval, and she has found the answer in fungi.
The SIKU platform supports Indigenous knowledge and data sovereignty. Watch the demonstration led by Candice Sudlovenick from the Arctic Eider Society.